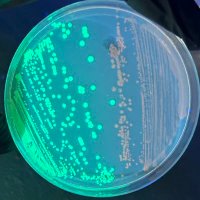
Daniel S. (@asecretcrow) 's Twitter Profile

Daniel S.
@asecretcrow
@columbia @igisci you and I are earth 🧬synthetic biology 🧫genetic engineering 🎨 art history
ID: 879168904324665345
26-06-2017 02:46:15
15,15K Tweet
492 Takipçi
5,5K Takip Edilen
@asecretcrow
@columbia @igisci you and I are earth 🧬synthetic biology 🧫genetic engineering 🎨 art history
ID: 879168904324665345
26-06-2017 02:46:15
15,15K Tweet
492 Takipçi
5,5K Takip Edilen